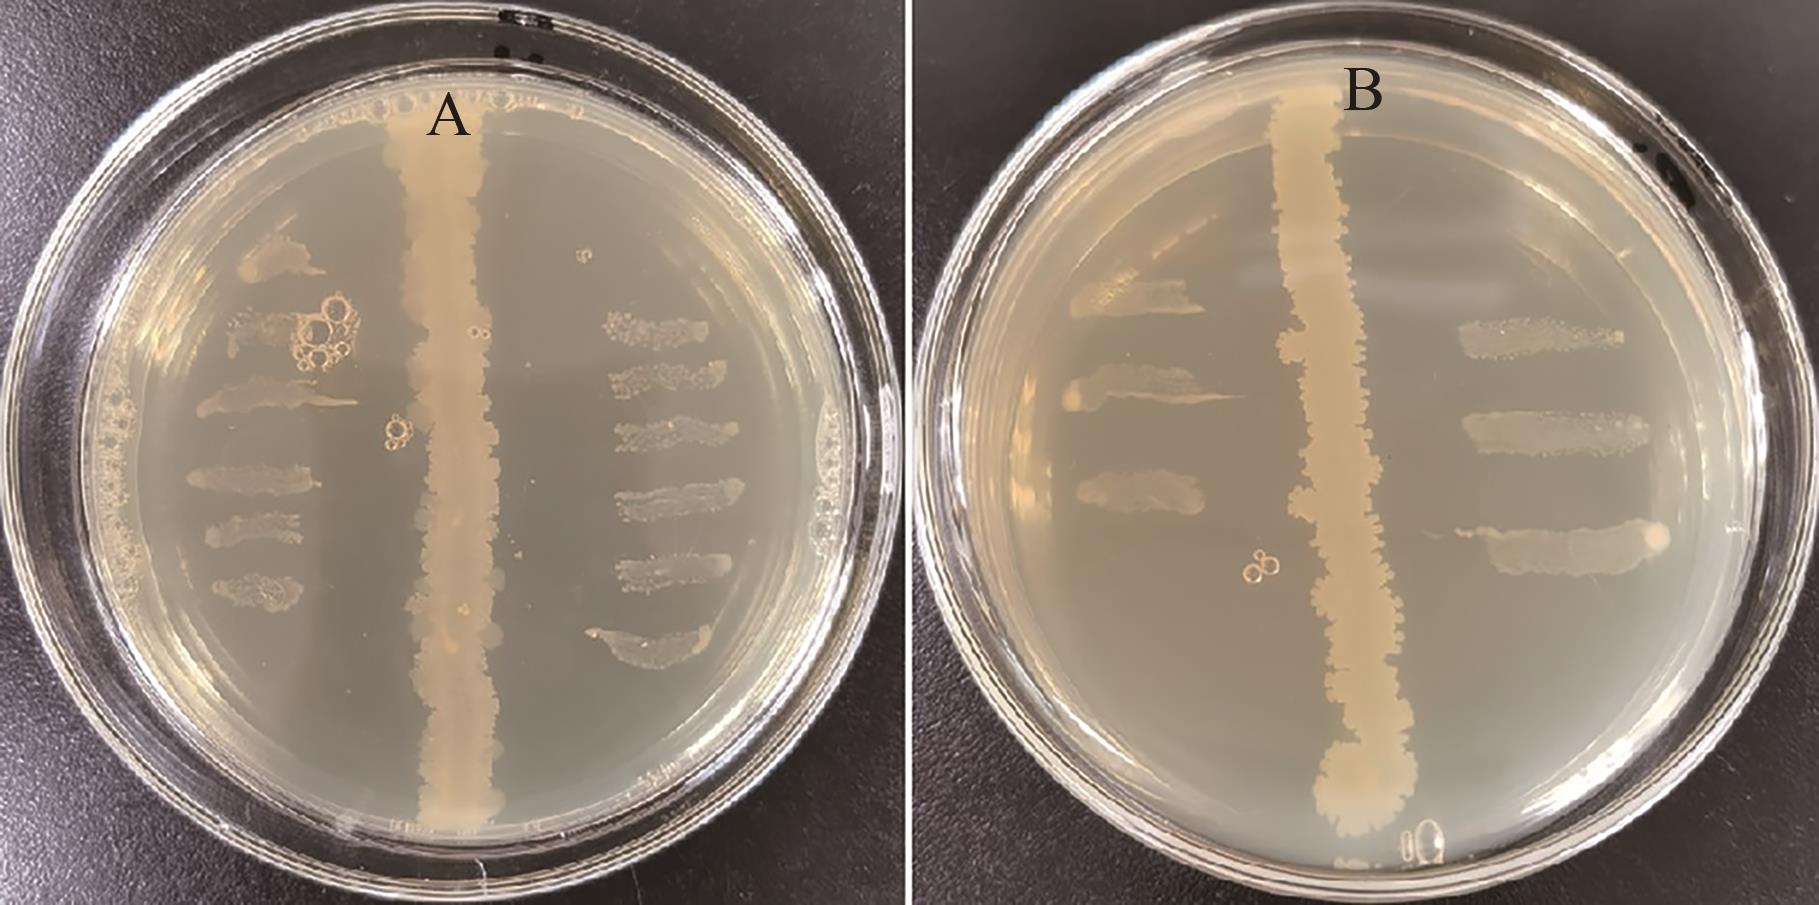
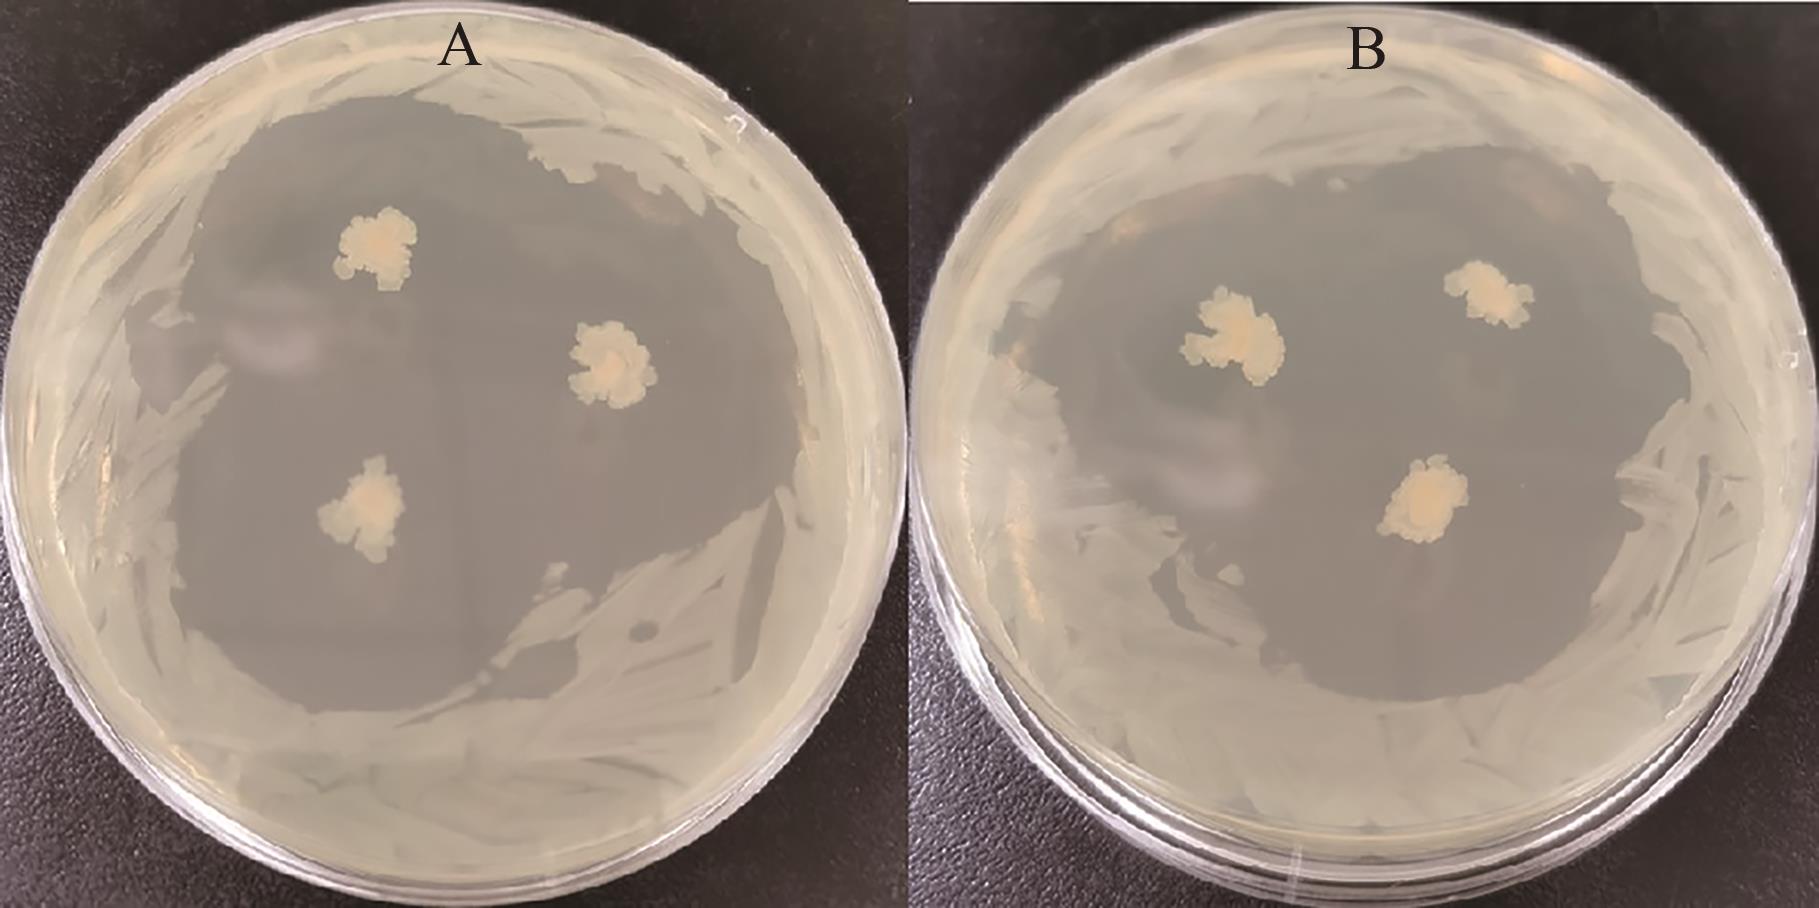

中国农业科技导报 ›› 2025, Vol. 27 ›› Issue (8): 119-131.DOI: 10.13304/j.nykjdb.2024.0457
李海利1,2( ), 杨帆2, 陈建豪2, 杨康2, 杨夷平2, 段进刚2, 李斌2, 张婉琪2, 马春江2
), 杨帆2, 陈建豪2, 杨康2, 杨夷平2, 段进刚2, 李斌2, 张婉琪2, 马春江2
收稿日期:2024-06-06
接受日期:2024-09-24
出版日期:2025-08-15
发布日期:2025-08-26
作者简介:李海利E-mail: haili8693@sina.com
基金资助:
Haili LI1,2( ), Fan YANG2, Jianhao CHEN2, Kang YANG2, Yiping YANG2, Jingang DUAN2, Bin LI2, Wanqi ZHANG2, Chunjiang MA2
), Fan YANG2, Jianhao CHEN2, Kang YANG2, Yiping YANG2, Jingang DUAN2, Bin LI2, Wanqi ZHANG2, Chunjiang MA2
Received:2024-06-06
Accepted:2024-09-24
Online:2025-08-15
Published:2025-08-26
摘要:
为筛选对同时携带新德里金属β-内酰胺酶(New Delhi metal-β-lactamase,NDM)基因NDM1/NDM5和NDM4/NDM5的超级耐药大肠杆菌抑菌活性较好的药用植物内生菌,采用表面消毒法和平板对峙法分离筛选对同时携带NDM1/NDM5和NDM4/NDM5的超级耐药大肠杆菌有拮抗作用的连翘内生菌,通过形态学和分子生物学鉴定,并结合全基因组学分析探究其抗菌活性物质。结果表明,从连翘根、茎、叶和果中分离得到23株内生菌。采用平板对峙法抑菌试验,从23株内生菌中获得1株抗菌效果较好的革兰氏阳性内生菌HNYJ2209J,经形态学鉴定和分子鉴定为类芽孢杆菌(Paenibacillus sp),该菌能有效抑制超级耐药大肠杆菌的活性。对HNYJ2209J菌株进行全基因组测序分析,其基因组大小为5 827 342 bp,GC含量为46.22%,预测其编码基因为5 232个,其中被NR、Swiss-Prot、COG、GO、KEGG数据库注释的基因数分别为5 229、3 648、4 107、3 493和2 495。通过antiSMASH预测到8个与次级代谢产物合成相关的基因簇;主要次级代谢产物有环脂肽类抗生素、十三肽菌素、多粘菌素B、抗菌肽、噻唑环肽类化合物、拉索肽、脂质庚肽和多烯聚酮类化合物。其中,脂肽类抗生素、十三肽菌素、多粘菌素B和抗菌肽的预测合成基因簇与已知基因簇的同源性分别为100%、100%、100%和90%。综上表明,HNYJ2209J菌株具有开发针对同时携带NDM1/NDM5和NDM4/NDM5超级耐药大肠杆菌的新药和作为可饲用微生物的潜力。
中图分类号:
李海利, 杨帆, 陈建豪, 杨康, 杨夷平, 段进刚, 李斌, 张婉琪, 马春江. 类芽孢杆菌对携带NDM基因的超级耐药大肠杆菌的抑菌活性分析[J]. 中国农业科技导报, 2025, 27(8): 119-131.
Haili LI, Fan YANG, Jianhao CHEN, Kang YANG, Yiping YANG, Jingang DUAN, Bin LI, Wanqi ZHANG, Chunjiang MA. Analysis of Bacteriostasis Activity of Paenibacillus sp. Against Super Drug-resistant Escherichia coli Carrying NDM Genes[J]. Journal of Agricultural Science and Technology, 2025, 27(8): 119-131.
图1 拮抗菌株的筛选A:携带NDM1/NDM5的超级耐药大肠杆菌;B:携带NDM4/NDM5的超级耐药大肠杆菌
Fig. 1 Screening of antagonistic strainsA: Super-resistant E. coli carrying NDM1/NDM5 B: Super drug-resistant E. coli carrying NDM4/NDM5
图2 菌株HNYJ2209J对超级耐药大肠杆菌的拮抗试验A:携带NDM1/NDM5的超级耐药大肠杆菌;B:携带NDM4/NDM5的超级耐药大肠杆菌
Fig. 2 Antagonism test of strain HNYJ2209J on super drug-resistant E. coliA: Super-resistant E. coli carrying NDM1/NDM5 B: Super drug-resistant E. coli carrying NDM4/NDM5

图4 菌株HNYJ2209J的16S rRNA PCR结果注:M—Marker;1~3—HNYJ2209J的3次生物学重复。
Fig. 4 16S rRNA PCR result of strain HNYJ2209JNote:M—Marker; 1~3—3 biological replicates of HNYJ2209J.

图6 HNYJ2209J菌株发酵液对超级耐药大肠杆菌的抑菌效果A:携带NDM1/NDM5的超级耐药大肠杆菌;B:携带NDM4/NDM5的超级耐药大肠杆菌
Fig. 6 Inhibitory effect of strain HNYJ2209J on super drug-resistant E. coliA: Super-resistant E. coli carrying NDM1/NDM5 B: Super drug-resistant E. coli carrying NDM4/NDM5
功能分类 Functional classification | 基因数 Number of genes |
|---|---|
| 辅助氧化还原酶(Auxiliary activities,AAs) | 2 |
| 碳水化合物结合模块(Carbohydrate-binding modules,CBMs) | 26 |
| 碳水化合物酯酶(Carbohydrate esterases,CEs) | 32 |
| 糖苷水解酶(Glycoside hydrolases,GHs) | 125 |
| 糖基转移酶(Glycosyl transferases,GTs) | 33 |
| 多糖裂合酶(Polysaccharide lyases,PLs) | 1 |
表2 CAZy数据库注释结果
Table 2 Annotation results of CAZy database
功能分类 Functional classification | 基因数 Number of genes |
|---|---|
| 辅助氧化还原酶(Auxiliary activities,AAs) | 2 |
| 碳水化合物结合模块(Carbohydrate-binding modules,CBMs) | 26 |
| 碳水化合物酯酶(Carbohydrate esterases,CEs) | 32 |
| 糖苷水解酶(Glycoside hydrolases,GHs) | 125 |
| 糖基转移酶(Glycosyl transferases,GTs) | 33 |
| 多糖裂合酶(Polysaccharide lyases,PLs) | 1 |
类型 Type | 簇ID Cluster ID | 基因位置 Genome location | 最相似的基因簇 Most similar known cluster | 序列一致性 Similarity of sequence/% |
|---|---|---|---|---|
| 非核糖体多肽合成酶Non-ribosomal peptide synthetase | Cluster 1 | 68 140~130 725 | 环脂肽类抗生素B Fusariciden B | 100 |
| Cluster 2 | 341 060~362 265 | - | - | |
| Cluster 7 | 1 433 971~1 494 636 | 噻唑环肽类化合物AMarthiapeptide A | ||
| Cluster 9 | 2 042 324~2 103 728 | - | - | |
| Cluster 10 | 2 469 235~2 562 320 | 十三肽菌素Tridecaptin | 100 | |
| Cluster 11 | 2 720 521~2 845 826 | 脂质庚肽Paenilipoheptin | 19 | |
| Cluster 12 | 2 944 761~2 997 159 | - | - | |
| Cluster 17 | 5 001 683~5 082 857 | 多粘菌素BPolymyxin B | 100 | |
| 羊毛硫肽类化合物Lanthipeptide | Cluster 3 | 994 616~1 020 919 | 细菌抗菌肽Paenibacillin | 90 |
| Cluster 16 | 4 869 313~4 892 543 | - | ||
| TransAT-PKS | Cluster 4 | 1 042 831~1 119 499 | - | - |
| Proteusin | Cluster 5 | 1 220 795~1 241 031 | - | - |
| 套索肽Lassopeptide | Cluster 6 | 1 356 777~1 380 842 | 拉索肽Paeninodin | 40 |
| 循环-内酯Cyclic-lactone | Cluster 8 | 1 800 731~1 819 131 | - | - |
| Cluster 13 | 3 140 538~3 160 684 | - | - | |
| TransAT-PKS-like | Cluster 14 | 3 639 549~3 741 439 | Aurantinin B/C/D | 35 |
| Ranthipeptide | Cluster 15 | 4 502 063~4 527 449 | - |
表3 菌株HNYJ2209J基因组中编码次生代谢物的基因簇列表
Table 3 List of gene clusters encoding secondary metabolites in the genome of strain HNYJ2209J
类型 Type | 簇ID Cluster ID | 基因位置 Genome location | 最相似的基因簇 Most similar known cluster | 序列一致性 Similarity of sequence/% |
|---|---|---|---|---|
| 非核糖体多肽合成酶Non-ribosomal peptide synthetase | Cluster 1 | 68 140~130 725 | 环脂肽类抗生素B Fusariciden B | 100 |
| Cluster 2 | 341 060~362 265 | - | - | |
| Cluster 7 | 1 433 971~1 494 636 | 噻唑环肽类化合物AMarthiapeptide A | ||
| Cluster 9 | 2 042 324~2 103 728 | - | - | |
| Cluster 10 | 2 469 235~2 562 320 | 十三肽菌素Tridecaptin | 100 | |
| Cluster 11 | 2 720 521~2 845 826 | 脂质庚肽Paenilipoheptin | 19 | |
| Cluster 12 | 2 944 761~2 997 159 | - | - | |
| Cluster 17 | 5 001 683~5 082 857 | 多粘菌素BPolymyxin B | 100 | |
| 羊毛硫肽类化合物Lanthipeptide | Cluster 3 | 994 616~1 020 919 | 细菌抗菌肽Paenibacillin | 90 |
| Cluster 16 | 4 869 313~4 892 543 | - | ||
| TransAT-PKS | Cluster 4 | 1 042 831~1 119 499 | - | - |
| Proteusin | Cluster 5 | 1 220 795~1 241 031 | - | - |
| 套索肽Lassopeptide | Cluster 6 | 1 356 777~1 380 842 | 拉索肽Paeninodin | 40 |
| 循环-内酯Cyclic-lactone | Cluster 8 | 1 800 731~1 819 131 | - | - |
| Cluster 13 | 3 140 538~3 160 684 | - | - | |
| TransAT-PKS-like | Cluster 14 | 3 639 549~3 741 439 | Aurantinin B/C/D | 35 |
| Ranthipeptide | Cluster 15 | 4 502 063~4 527 449 | - |
基因ID Gene ID | 毒力因子ID编号 VFDB ID | 毒力因子名称 Vfs | 序列一致性 Identity/% |
|---|---|---|---|
| Gene0185 | VFG000077(gb|NP_465991) | ClpP(VF0074) | 69.05 |
| Gene01193 | VFG050186(gb|AJI07989.1) | BpsC (CVF891) | 71.58 |
| Gene01194 | VFG050185(gb|AJI07977.1) | BpsD (CVF891) | 63.73 |
| Gene01214 | VFG050185(gb|AJI07977.1) | BpsD (CVF891) | 61.31 |
| Gene01261 | VFG012095(gb|YP_001086664) | GroEL (VF0594) | 70.71 |
| Gene01364 | VFG002158(gb|NP_464456) | LpIAI (VF0347) | 61.63 |
| Gene01805 | VFG039282(gb|NP_819314) | CBU (CVF803) | 63.01 |
| Gene02451 | VFG000077(gb|NP_465991) | ClpP (VF0074) | 64.17 |
| Gene03327 | VFG006717(gb|NP_465159) | Lap (VF0444) | 63.74 |
| Gene03414 | VFG048830(gb|YP_002920353.1) | Capsule (VF0560) | 68.59 |
| Gene04258 | VFG000077(gb|NP_465991) | ClpP (VF0074) | 65.82 |
| Gene04825 | VFG046465(gb|YP_169203.1) | EF-Tu (VF0460) | 72.84 |
| Gene04856 | VFG000079(gb|NP_463763) | ClpC (VF0072) | 76.20 |
| Gene04883 | VFG050186(gb|AJI07989.1) | BpsC (CVF891) | 64.77 |
表4 HNYJ2209J菌株毒力基因预测
Table 4 Virulence gene prediction of HNYJ2209J strain
基因ID Gene ID | 毒力因子ID编号 VFDB ID | 毒力因子名称 Vfs | 序列一致性 Identity/% |
|---|---|---|---|
| Gene0185 | VFG000077(gb|NP_465991) | ClpP(VF0074) | 69.05 |
| Gene01193 | VFG050186(gb|AJI07989.1) | BpsC (CVF891) | 71.58 |
| Gene01194 | VFG050185(gb|AJI07977.1) | BpsD (CVF891) | 63.73 |
| Gene01214 | VFG050185(gb|AJI07977.1) | BpsD (CVF891) | 61.31 |
| Gene01261 | VFG012095(gb|YP_001086664) | GroEL (VF0594) | 70.71 |
| Gene01364 | VFG002158(gb|NP_464456) | LpIAI (VF0347) | 61.63 |
| Gene01805 | VFG039282(gb|NP_819314) | CBU (CVF803) | 63.01 |
| Gene02451 | VFG000077(gb|NP_465991) | ClpP (VF0074) | 64.17 |
| Gene03327 | VFG006717(gb|NP_465159) | Lap (VF0444) | 63.74 |
| Gene03414 | VFG048830(gb|YP_002920353.1) | Capsule (VF0560) | 68.59 |
| Gene04258 | VFG000077(gb|NP_465991) | ClpP (VF0074) | 65.82 |
| Gene04825 | VFG046465(gb|YP_169203.1) | EF-Tu (VF0460) | 72.84 |
| Gene04856 | VFG000079(gb|NP_463763) | ClpC (VF0072) | 76.20 |
| Gene04883 | VFG050186(gb|AJI07989.1) | BpsC (CVF891) | 64.77 |
| [1] | CHENG Z, AITHA M, THOMAS C A, et al.. Machine learning models identify inhibitors of New Delhi metallo-beta-lactamase [J]. J. Chem. Inf. Model., 2024, 64(10):3977-3991. |
| [2] | KWANKAEW P, SANGKANU S, MITSUWAN W, et al.. Inhibitory and anti-adherent effects of Piper betle L. leaf extract against Acanthamoeba triangularis in co-infection with Staphylococcus aureus and Pseudomonas aeruginosa: a sustainable one-health approach [J]. Vet. World., 2024, 17(4):848-862. |
| [3] | 王晓晴,刘博,王子墨,等.曼陀罗内生真菌Fusarium solani MBM-5活性次级代谢产物研究[J].中国中药杂志,2024,49(10):2722-2727. |
| [4] | BARRETO RAMOS D G, GURGEL AMARAL A G, DUARTE I G, et al.. Endophytic species of Colletotrichum associated with cashew tree in northeastern Brazil [J]. Fungal. Biol., 2024, 128(3):1780-1789. |
| [5] | WANG W H, LI C R, QIN X J, et al.. Novel Alkaloids from Aspergillus fumigatus VDL36, an endophytic fungus associated with Vaccinium dunalianum [J]. J. Agric. Food. Chem., 2024, 72(19):10970-10980. |
| [6] | TRAPP MA, KAI M, MITHOFER A. RODRIGUES-FILHO E. Antibiotic oxylipins from Alternanthera brasiliana and its endophytic bacteria [J]. Phytochemistry, 2015, 110:72-82. |
| [7] | LIU H X, LIU Z M, ZHANG Y J, et al.. Antioxidant aryl-substituted phthalan derivatives produced by endophytic fungus Cytospora rhizophorae [J/OL]. Front. Chem., 2022, 10:826615 [2024-05-10]. . |
| [8] | YIN G P, GONG M, XUE G M, et al.. Penispidins A-C, Aromatic sesquiterpenoids from Penicillium virgatum and their inhibitory effects on hepatic lipid accumulation [J]. J. Nat. Prod., 2021, 84(10):2623-2629. |
| [9] | GUO Z, CHEN B, CHEN D, et al.. New Isocoumarin and pyrone derivatives from the Chinese mngrove plant Rhizophora mangle-associated fungus Phomopsis sp. DHS-11 [J]. Molecules, 2023, 28(9):125-135. |
| [10] | GUPTA A, MESHRAM V, GUPTA M, et al.. Fungal endophytes: microfactories of novel bioactive compounds with therapeutic interventions; a comprehensive review on the biotechnological developments in the field of fungal endophytic biology over the last decade [J]. Biomolecules, 2023, 13(7):213-223 |
| [11] | KANTARI S A K, BISWAL R P, KUMAR P, et al.. Antioxidant and antidiabetic activities, and UHPLC-ESI-QTOF-MS-based metabolite profiling of an endophytic fungus Nigrospora sphaerica BRN 01 isolated from Bauhinia purpurea L. [J]. Appl. Biochem. Biotechnol., 2023, 195(12):7465-7482. |
| [12] | CASTILLO U F, STROBEL G A, FORD E J, et al.. Munumbicins, wide-spectrum antibiotics produced by Streptomyces NRRL 30562, endophytic on Kennedia nigriscans [J]. Microbiology, 2002, 148(9):2675-2685. |
| [13] | HUA H, ZHANG X, YAO Y, et al.. Complete genome sequence of a novel mitovirus identified in the phytopathogenic fungus Fusarium oxysporum F. sp. melonis strain T-SD3 [J/OL]. Arch. Virol., 2024, 169(6):126 [2024-05-10]. . |
| [14] | LI H, GAO S, SHI S, et al.. Rational construction of genome-minimized Streptomyces host for the expression of secondary metabolite gene clusters [J]. Synth. Syst. Biotechnol., 2024, 9(3):600-608. |
| [15] | WEN Y, LV Y, HAO J, et al.. Two new compounds of Penicillium polonicum, an endophytic fungus from Camptotheca acuminata Decne [J]. Nat. Prod. Res., 2020, 34(13):1879-1883. |
| [16] | 李海利,郎利敏,张青娴,等.同时产碳青霉烯酶NDM5和NDM的大肠埃希氏菌的鉴定及耐药性研究[J].生物技术通报,2022,28(9):106-115. |
| LI H L, LANG L M, ZHANG Q X, et al.. Identification and drug resistance of Escherichia coli simultaneously producing carbapenemase NDM-1 and NDM-5 [J]. Biotechnol. Bull., 2022, 28(9):106-115. | |
| [17] | 李海利,张青娴,朱文豪,等。携带新德里金属β-内酰胺酶的猪源大肠杆菌全基因组测序分析及敏感植物提取物药物筛选研究[J].中国兽药杂志,2023,57(6):23-33. |
| LI H L, ZHANG Q X, ZHU W H, et al.. Whole genome sequencing analysis of Escherichia coli from pigs carrying delhi metal β-lactamase and drug screening of sensitive plant extracts [J]. Chin. J. Vet. Drug, 2023, 57(6):23-33. | |
| [18] | AL-BAYSSARI C, NAWFAL DAGHER T, HAMOUI S E L, et al.. Carbapenem and colistin-resistant bacteria in North Lebanon: coexistence of mcr-1 and NDM-4 genes in Escherichia coli [J]. J. Infect. Dev. Countries, 2021, 15(7):934-342. |
| [19] | MEHAFFEY M R, AHN Y C, RIVERA D D, et al.. Elusive structural changes of New Delhi metallo-beta-lactamase revealed by ultraviolet photodissociation mass spectrometry [J]. Chem. Sci., 2020, 11(33):8999-9010. |
| [20] | RAHMAN M, SHUKLA S K, PRASAD K N, et al.. Prevalence and molecular characterisation of New Delhi metallo-beta-lactamases NDM-1, NDM-5, NDM-6 and NDM-7 in multidrug-resistant Enterobacteriaceae from India [J]. Int. J. Antimicrob. Agents., 2014, 44(1):30-37. |
| [21] | ZHANG Y, ZHANG Q, LI C, et al.. Advances in cell membrane-based biomimetic nanodelivery systems for natural products [J/OL]. Drug. Deliv., 2024, 31(1):23611696 [2024-05-10]. . |
| [22] | MAMANGKEY J, MENDES L W, MUSTOPA A Z, et al.. Endophytic Aspergillii and Penicillii from medicinal plants: a focus on antimicrobial and multidrug resistant pathogens inhibitory activity [J]. Biol. Technol., 2024, 105(1):83-95. |
| [23] | MARYAM H, FAZEL P, MOSTAFA N. Isolation and screening of antibacterial activity of Actinomycetota from the medicinal plant, Anthemis pseudocotula Boiss [J]. Archives Razi Institute, 2023, 78(5):1638-1646. |
| [24] | 刘玉珍,高飞,马雪燕,等.连翘中具有药物活性成分内生菌的筛选及其拮抗特性的研究[J].延安大学学报(自然科学版),2024,4(33):84-88. |
| LIU Y Z, GAO F, MA X Y, et al.. Screening of drug active products endophytic from Fructus Forsythiae and study on their antagonism [J]. J. Yanan Univ. (Nat. Sci.), 2024, 4(33):84-88. | |
| [25] | 杨雪.高产连翘苷内生真菌Colletotriclum gloeosporioides的诱变选育[D].西安:陕西师范大学,2014. |
| YANG X. Mutagenesis and breeding of endophytic fungus Colletotriclum gloeosporioides with high yield of forsythin [D]. Xi’an: Shaanxi Normal University, 2014. | |
| [26] | 翼玉良,李丹青,李堆淑,等.连翘内生菌的分离及对植物病原菌的抑菌活性测定[J].西南农业学报,2011,246:2258-2262. |
| YI Y L, LI D Q, LI D S, et al.. Isolation of endophyte from Fructus forsythiae and determination of its inhibition activities to plant pathogens [J]. Southwest Agric. J., 2011, 24(6):2258-2262 | |
| [27] | 袁保红,杜青平,胡立勇.小连翘内生放线菌YBL-02菌株的初步鉴定和发酵产物分离[J].中国现代应用药学杂志,2009,5(26):360-363. |
| YUAN B H, DU Q P, HU L Y. Taxonomy, fermentation and products characterization of actinomycete strain YBL-02 from Hyperioums sampsonii Hance [J]. Chin. J. Modern Appl. Pharmacy, 2009, 5(26):360-363. | |
| [28] | NADEEM H, NIAZI P, ASIF M, et al.. Bacterial strains integrated with surfactin molecules of Bacillus subtilis MTCC441 enrich nematocidal activity against Meloidogyne incognita [J]. Plant Biol., 2021, 23(6):1027-1036. |
| [29] | KIM Y T, KIM S E, LEE W J, et al.. Isolation and characterization of a high iturin yielding Bacillus velezensis UV mutant with improved antifungal activity [J/OL]. PLoS One, 2020, 15(12):e0234177 [2024-05-10]. . |
| [30] | FANAEI M, JURCIC K, EMTIAZI G. Detection of simultaneous production of kurstakin, fengycin and surfactin lipopeptides in Bacillus mojavensis using a novel gel-based method and MALDI-TOF spectrometry [J]. World J. Microbiol. Biotechnol., 2021, 37(6):97-107. |
| [31] | SHARMA D, SINGH S S, BAINDARA P, et al.. Surfactin like broad spectrum antimicrobial lipopeptide co-produced with sublancin from Bacillus subtilis strain A52: dual reservoir of bioactives [J]. Front. Microbiol., 2020, 11:1167-1177. |
| [32] | GAN P, JIN D, ZHAO X, et al.. Bacillus-produced surfactin attenuates chronic inflammation in atherosclerotic lesions of ApoE(-/-) mice [J]. Int. Immunopharmacol., 2016, 35:226-234. |
| [33] | 都海明,戚广州,王建军,等.抗菌脂肽对断奶仔猪生长性能、肠道微生物及血液指标的影响研究[J].中国粮油学报,2011,26(5):76-82. |
| DU H M, QI G Z, WANG J J, et al.. Effects of antimicrobial lipopeptides on performance, intestinal microflora and blood biochemical parameters in weaned pigs [J]. J. Chin. Cereals Oils Assoc., 2011, 26(5):76-82. | |
| [34] | 翟少伟,李剑,孙秀文.饲料中添加表面活性素对吉富罗非鱼生长性能、血清生化指标及脂肪代谢的影响[J].动物营养学报,2015,27(12):3959-3967. |
| ZHAI S W, LI J, SUN X W. Effects of surfactin supplementation on growth performance, serum biochemical indexes and lipid metabolism of genetically improved farmed tilapia (Oreochromis niloticus) [J]. Chin. J. Anim. Nutr., 2015, 27(12):3959-3967. |
| [1] | 纪蕾, 刘天红, 王颖, 李晓, 李红艳, 孙元芹, 姜晓东. 载银氧化壳聚糖的制备与抑菌性能研究[J]. 中国农业科技导报, 2024, 26(3): 214-222. |
| [2] | 马蓝, 彭晴, 徐小轻, 杨硕, 张宇微, 田丹丹, 施琳波, 石波, 乔宇. 大肠杆菌O157∶H7生物被膜状态下基因表达分析[J]. 中国农业科技导报, 2023, 25(6): 71-88. |
| [3] | 胡茜, 王艺凝, 申鹏飞, 李雅倩, 杨阳, 王艳成, 姬文秀, 董微巍. 洋虫内产β-葡萄糖苷酶内生菌发酵液转化人参皂苷产物分析及其抗肿瘤活性研究[J]. 中国农业科技导报, 2023, 25(2): 119-127. |
| [4] | 李宏博, 陈月月, 杨玉洁, 徐琦琦, 秦蕾, 蔡鑫, 夏利宁. 新疆伊犁昭苏健康鸡源大肠杆菌耐药性及耐药基因分析[J]. 中国农业科技导报, 2023, 25(11): 123-131. |
| [5] | 张豫丹, 王卫民, 倪博, 马晓寒, 李俊领, 许自成, 贾玮, 史久长. 烟草秸秆绿原酸提取工艺优化及其抑菌效果研究[J]. 中国农业科技导报, 2023, 25(1): 119-127. |
| [6] | 王新南1,罗家豪1,郝俊杰2,张晓艳2,刘璐1,付丽平1,王家林1,韩燕红3,刘全兰1*. 蚕豆幼苗内生固氮菌促生长特性的研究[J]. 中国农业科技导报, 2020, 22(6): 33-39. |
| [7] | 张凯晔1,2,刘晓琳2,董小燕2,3,刘润进4,贺立恒1*,解志红2,3*. 田菁种子内生菌的分离及其对萌发的影响[J]. 中国农业科技导报, 2020, 22(6): 40-48. |
| [8] | 王楠1,李刚强1,李云龙2,李永斌2,张浩玮2,王民洋2,王莉瑛2,刘德虎1,陈三凤2*. 固氮类芽孢杆菌的分离鉴定及其促生、抑菌活性的测定[J]. 中国农业科技导报, 2019, 21(5): 95-103. |
| [9] | 崔旭盛1,2,靳鹏博1,李鑫1,3,宗建新1,3,祁飞1,高秀强1,刘灵娣4*,胡肖肖4,谢超5. 不同加工方式对连翘药材品质的影响[J]. 中国农业科技导报, 2019, 21(5): 129-134. |
| [10] | 卢瑞克1,高雪飞2,刘灵娣1*,温春秀1,谢晓亮1*,田伟1,贾东升1,刘铭1,欧阳艳飞1. 插穗类型及直径对连翘扦插育苗的影响[J]. 中国农业科技导报, 2019, 21(2): 41-45. |
| [11] | 江萍§,程伟华§,林亚军,夏绪进,夏利宁*. 春秋两季不同地区猪源耐药大肠杆菌β-内酰胺酶及16S rRNA甲基化酶基因检测及分析[J]. 中国农业科技导报, 2017, 19(5): 35-41. |
| [12] | 吴思梦,刘冰*,蒋军喜,刘英,周珍. 生防链霉菌ML27和柑橘内生放线菌P3Y2原生质体融合研究[J]. 中国农业科技导报, 2017, 19(3): 31-36. |
| [13] | 程伟华,夏利宁*,夏绪进,王营彬. 新疆塔城地区不同来源大肠杆菌的耐药性调查[J]. , 2015, 17(3): 152-158. |
| [14] | 高娟,夏利宁*,夏绪进,程伟华. 新疆克拉玛依市猪源大肠杆菌耐药性调查[J]. , 2014, 16(6): 103-108. |
| [15] | 孙乔乔1,谭笑2,吕依2,黄火清2,张会图1*,路福平1. 嗜热真菌Neosartorya fischeri P1脂肪酶基因的克隆、表达及酶学性质分析[J]. , 2014, 16(5): 53-59. |
| 阅读次数 | ||||||
|
全文 |
|
|||||
|
摘要 |
|
|||||